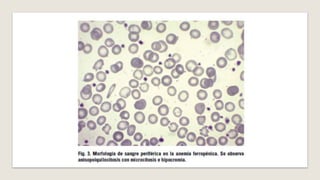
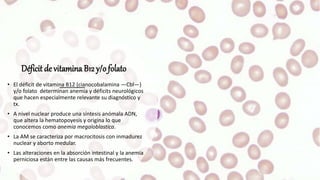
Déficit de vitamina B12 y/o folato
• El déficit de vitamina B12 (cianocobalamina —Cbl—)
y/o folato determinan anemia y déficits neurológicos
que hacen especialmente relevante su diagnóstico y
tx.
• A nivel nuclear produce una síntesis anómala ADN,
que altera la hematopoyesis y origina lo que
conocemos como anemia megaloblastica.
• La AM se caracteriza por macrocitosis con inmadurez
nuclear y aborto medular.
• Las alteraciones en la absorción intestinal y la anemia
perniciosa están entre las causas más frecuentes.
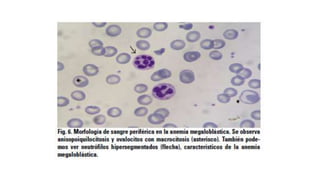

La anemia se define como la disminución de la masa eritrocitaria, siendo clasificada por la OMS en varios tipos según sus causas y características. Los síntomas incluyen astenia, palidez y, en casos severos, signos de insuficiencia cardíaca. La epidemiología revela que más de 1.500 millones de personas en el mundo padecen anemia, con el déficit de hierro siendo la causa más común.